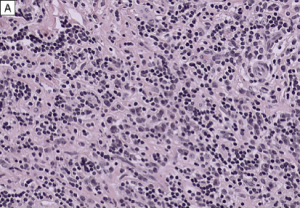
Figure 1A igg4.png

IgG4-related Orbital Inflammation
All content on Eyewiki is protected by copyright law and the Terms of Service. This content may not be reproduced, copied, or put into any artificial intelligence program, including large language and generative AI models, without permission from the Academy.
IgG4-related disease (IgG4-RD) is a systemic condition in which fibroinflammatory lesions rich in IgG4+ plasma cells can be present in single or multiple organs of the body. When the disease manifests in the eye or orbit, it is referred to as IgG4-related ophthalmic disease (IgG4-ROD), which most commonly causes painless swelling of the lacrimal gland(s). Other commonly affected parts of the eye and orbit include the extraocular muscles, orbital fat, infraorbital nerve, eyelid, and the nasolacrimal duct system. Diagnostic criteria combine physical examination, imaging, and histopathologic findings detailing the number of IgG4+ cells/high-power microscopic field (HPF) and the ratio of IgG4+ to IgG+ cells/HPF. Imaging can aid in diagnosis and tissue biopsy is necessary to exclude other conditions on the differential such as malignancy. Medical treatments with corticosteroids and/or immunosuppressants such as rituximab are the mainstay of therapy. Observation, radiotherapy, and surgical resection have had variable results.
Disease Entity
IgG4-Related Orbital Inflammation Otherwise known as: Orbital IgG4-related disease, IgG4-related orbital pseudotumor, IgG4-related ophthalmic disease (IgG4-ROD).
History
IgG4-RD was first presented in 2001 in a Japanese study of patients with autoimmune pancreatitis who were found to have elevated serum IgG4 levels.[1] Subsequently, many autoimmune pancreatitis patients were found to have fibroinflammatory lesions in other areas and organs of the bodies including the biliary tree, retroperitoneum, salivary glands, orbit, lymph nodes, kidneys, lungs, meninges, aorta, breast, prostate, thyroid, pericardium, and skin.[2] The orbit was the first extra-pancreatic site of IgG4-RD reported in the literature.[3]
Definition
IgG4-RD is a systemic inflammatory disorder in which fibrosing lesions may be found in various areas and organs of the body.[4] IgG4-RD is the umbrella term for systemic disease, while IgG4-ROD is the more specific term for manifestations in the eye and orbit.
Incidence
IgG4-ROD has been shown to constitute 17-60% of cases diagnosed as idiopathic orbital inflammation. [5][6][7][8] In Japan, the incidence of autoimmune pancreatitis secondary to IgG4-RD is reported to be 0.28-1.08 cases per 100,00 people.[9][10] Since IgG4-RD may go undiagnosed and the above figure does not take into account extra-pancreatic sites of involvement, it is thought that the true incidence is higher.[11] Incidence has not yet been reported in the US.
Epidemiology in the pediatric population is also unknown, as there are few reported cases among children. Ocular involvement was found in 44% of pediatric patients with IgG4-RD, and cases range from 5-15 years of age.[12]
Frequency of IgG4-ROD Location
The lacrimal gland is the most commonly involved site in IgG4-ROD (62-88%).[5][13][14][15][16] Other common sites include the trigeminal nerve (9.5-39%), extraocular muscles (19-25%), orbital fat (28.6-40%), eyelid (12%), and the nasolacrimal duct system (1.5-9.5%).[10][17] Less commonly, IgG4-ROD may affect the sclera.[11]
Risk Factors
IgG4-RD, particularly autoimmune pancreatitis, tends to occur more often in older males compared to females (2.8-7.5:1).[18][19] However, for IgG4-ROD, disease tends to occur in a younger group of patients (55 years versus 58-69 years), affect men and women more equally (1.3:1), and be associated with salivary gland lesions and a higher serum IgG4 level.[20] IgG4-ROD has also been found to be associated with asthma and allergic rhinitis, as well as the rare syndrome adult-onset asthma and periocular xanthogranuloma (AAPOX).[21][22][23] IgG4-ROD patients may have an increased risk of non-Hodgkin lymphoma compared to patients with the pancreatic form of IgG4-RD.[18]
General Pathology
There are 3 major pathologic features of IgG4-RD:
- Dense lymphoplasmacytic infiltrate
- Focally storiform fibrosis
- Obliterative phlebitis
The diagnosis of IgG4-RD can usually be made when 2 of the 3 major features are present on pathology (most commonly the combination of a dense lymphoplasmacytic infiltrate and focally storiform fibrosis).[24] Minor pathologic features include non-obliterative phlebitis and mild to moderate tissue eosinophilia.[19] In IgG4-ROD, there are typically T-lymphocytes, and storiform fibrosis may not be present in lacrimal gland involvement.[11]When infraorbital nerve involvement is present, nerve fascicles tend to remain intact on pathology, as the disease involves the epineurium without fibrosis.[25] Other potential findings include germinal centers and obliterative arteritis (more common in the lung). The presence of histiocytes, granulomas, giant cells, or necrobiosis is unusual and suggests alternate diagnosis.
On immunohistochemistry, there should be >10 IgG4+ plasma cells/HPF (varies by organ system) and a ratio of IgG4+ plasma cells: IgG+ plasma cells >40%. In lacrimal gland disease, >100 IgG4+ cells/HPF are needed to make the diagnosis.
Pathophysiology
The etiology and pathogenesis of IgG4-ROD is currently unknown. Generally, pathogenesis is thought to revolve around humoral and cell-mediated immunity. Given that rituximab, which targets peripheral CD20+ naïve and memory B-cells, is an effective treatment for IgG4-ROD, one idea for pathogenesis is the indirect or direct effect of B-cell depletion on T-cell behavior.
In addition, certain subsets of patients with IgG4-RD are thought to have allergic mechanisms causing their disease. Some IgG4-RD patients with autoimmune pancreatitis are found to have symptoms of atopy, a history of allergy, or peripheral blood eosinophilia, as well as elevated serum IgE, implicating T-helper type 2 cells (Th2) in the pathogenesis. IgG4-ROD has previously been found to be associated with a significant increase in the expression of Th2 cytokines.[26] Th2 cells induce the production of cytokines IL-4, IL-5, and IL-13, which cause peripheral blood eosinophilia and elevation of both serum IgG4 and IgE.
Other theories of pathogenesis involve exposure to antigens in the upper aerodigestive tract and mucosal surfaces. Lacrimal glands affected by IgG4-ROD have previously been found to demonstrate somatic hypermutation, suggesting local immune response to antigen.[27]
Diagnosis
Clinical Presentation
Patients with IgG4-ROD most commonly have lacrimal gland involvement ( dacryoadenitis ) and tend to present with painless, unilateral or bilateral periorbital and/or eyelid swelling, erythema, and proptosis. Previously, bilateral lacrimal gland enlargement associated with salivary gland enlargement was referred to as Mikulicz’s disease, before the discovery of IgG4-RD as a unique clinical entity.[28] Compared to patients with traditional idiopathic orbital inflammation, IgG4-ROD patients are more likely to have bilateral and lacrimal involvement, and are less likely to achieve complete remission and more likely to experience recurrence after treatment. [7]
Involvement of extraocular muscles (EOMs) or orbital soft tissue is also associated with proptosis. EOM involvement may cause pain, diplopia, restrictive strabismus (less common than in Graves orbitopathy), and enlargement of the infraorbital canal/bone. The inferior rectus muscle is the most commonly affected EOM, followed by the superior rectus-levator complex, lateral rectus, medial rectus, inferior oblique, and superior oblique muscles.[15]
Less commonly, compressive optic neuropathy secondary to mass effect from inflammatory lesions may result in visual loss, afferent pupillary defect (APD), or visual field defects.[29] Mass effect can particularly occur in patients with infraorbital nerve enlargement, which is defined as the infraorbital nerve being greater in size than the optic nerve.[30] infraorbital nerve enlargement is significantly correlated with elevated serum IgG4 levels. Sensory loss is extremely rare.[31][32] Other less common manifestations are frontal nerve and perioptic nerve lesions.[33]
Rare cases of IgG4-ROD may present with isolated ocular findings such as conjunctivitis, scleritis, or uveitis.[11][34][35] Involvement of the nasolacrimal duct system can cause epiphora.[36] Very rarely, patients may present with destruction of bony structures comprising the orbit.[37][38]
Systemic involvement has been reported in 68% of patients with IgG4-ROD. The most common sites of involvement include the salivary glands (43%), lymph nodes (27%), and pancreas (20%).[39] [11][29][40][14] Risk factors for extraocular involvement include bilateral involvement, longer symptom duration, and higher serum IgG4 level.[41]
Imaging
Imaging can aid in diagnosis, especially in cases of orbital soft tissue or EOM involvement, which are better appreciated on orbital imaging. Imaging techniques include CT or MRI of the orbits, and fluorodeoxyglucose (FDG)-PET/CT scan. MRI will demonstrate isointensity on T1-weighted lesions, hypointensity on T2-weighted lesions, and homogenous gadolinium enhancing lesions.[42] FDG-PET scan can be used for systemic evaluation in IgG4-RD, as it can locate distant and/or clinically silent lesions.[43] There are currently no guidelines on how often FDG-PET/CT should be performed.
Clinical Diagnosis
Umehara et al. developed the following comprehensive diagnostic criteria for systemic IgG4-RD in 2012:[44]
- Clinical examination shows characteristic diffuse/localized swelling or masses in single or multiple organs.
- Hematologic examination shows elevated serum IgG4 concentrations (≥135 mg/dl).
- Histopathologic examination shows: (i) Marked lymphocyte and plasmacyte infiltration and fibrosis (ii) Infiltration of IgG4+ plasma cells: ratio of IgG4+ to IgG+ cells >40% and >10 IgG4+ plasma cells/HPF.
Definite IgG4-RD occurs when criteria 1, 2, and 3 are all present. Probable disease occurs when criteria 1 and 3 are present. Possible disease occurs when criteria 1 and 2 are present.
If diagnosis cannot be reached using the above comprehensive criteria, organ-specific diagnostic criteria may be used as well.
For ophthalmic and orbital disease, Goto et al. developed the following IgG4-ROD diagnostic criteria in 2015:[45]
- Imaging studies show enlargement of the lacrimal gland, trigeminal nerve, or extraocular muscle as well as masses, enlargement, or hypertrophic lesions in various ophthalmic tissues.
- Histopathologic examination shows marked lymphocyte and plasmacyte infiltration, and sometimes fibrosis. A germinal center is frequently observed. IgG4+ plasmacytes are found and satisfy the following criteria: ratio of IgG4+ cells to IgG+ cells of 40% or above, or more than 50 IgG4+ cells/HPF (x400).
- Blood test shows elevated serum IgG4 (≥135 mg/dl).
Definite IgG4-ROD is defined as 1, 2, and 3. Probable IgG4-ROD is defined as 1 and 2. Possible IgG4-ROD is defined as 1 and 3.
Diagnostic Procedures
Surgical biopsy of the lacrimal gland should be undertaken for histopathologic diagnosis of IgG4-ROD. Malignancy and other benign or infectious processes must be excluded through surgical biopsy and histopathology. If extra-orbital lymph node involvement is present, non-invasive lymph node biopsy may assist in diagnosis, as well.
Laboratory test
Elevated serum IgG4 levels may be present in IgG4-RD, although elevated IgG4 levels are neither necessary nor sufficient for the diagnosis. 40% of patients with biopsy-proven IgG4-RD will have a normal serum IgG4, and elevated IgG4 can be found in other disorders such as pancreatic adenocarcinoma, lymphoma, and ANCA-associated vasculitis.[46][47][48] The serum IgG4 level tends to be higher in patients with IgG4-ROD, bilateral disease, and in patients with extra-orbital disease.[11] Serum IgG4 levels may be used as a marker for treatment response in patients with IgG4-ROD, as levels were found to significantly decrease in patients after steroid treatment.[49] Patients who experience disease relapse after steroid treatment tend to have increasing serum IgG4 levels with a flare of symptoms. In addition, if serum IgG4 levels remain elevated after steroid treatment, this is predictive of IgG4-ROD relapse.
Other important labs include inflammatory markers such as ESR and CRP, as well as rheumatologic labs that help rule out similar forms of orbital inflammation on the differential. These include, but are not limited to, CBC and LDH (to rule out anemia secondary to lymphoproliferative disease), ANCA serologies (to distinguish IgG4-ROD from granulomatosis with polyangiitis (GPA)), Anti-Ro and Anti-La antibodies (to distinguish IgG4-ROD from Sjögren’s disease), ANA, ACE levels (to rule out sarcoidosis), T4, T3, TSH, thyroid-stimulating immunoglobulins (TSI), and anti thyroid antibodies (to rule out thyroid eye disease). One should also rule out orbital infections with mycobacterial and fungal stains and culture on pathology.
Differential diagnosis
- Granulomatosis with polyangiitis (GPA)
- Sjögren's disease
- Sarcoidosis
- Lymphoma (either primary ocular adnexal lymphoma or systemic lymphoma)
- Orbital infections (dacryoadenitis or orbital cellulitis caused by bacterial or fungal infections)
- Thyroid-related orbitopathy
- Idiopathic orbital inflammation
Management
General treatment
It is important to obtain tissue diagnosis prior to treatment in order to exclude malignancy.[3] Some patients with IgG4-ROD have been reported to achieve spontaneous remission under observation.[40] However, medical therapy is still considered first-line treatment and surgical resection is not generally employed.
Medical therapy
First-line therapy for IgG4-ROD is systemic corticosteroids. While no optimal steroid dose is known for IgG4-ROD, the international consensus guidelines on the management of IgG4-RD recommends 2-4 weeks of induction therapy with prednisone 0.6 mg/kg/day or 30 mg/day tapered over 8-12 weeks.[48] Initial response to systemic corticosteroids is excellent (89-100%), but relapse rates have been reported as high as 70% either during or after treatment.[39][48][50] Relapse tends to occur during taper (usually to less than 10 mg/day of prednisone) or after cessation of corticosteroid use.[39] Recurrence can be identified by increasing serum IgG4 levels and flare of symptoms related to inflammatory lesions, and occurs most frequently in the lacrimal gland.[11][39] Patients with lesions that are sclerotic on pathology tend to have less of a response to corticosteroid treatment.[3] Some practitioners may maintain patients on a maintenance dose of 5 mg/day of prednisolone, as this was shown to decrease relapse rates from 92% to 23% over a 3-year period.[18] Management of relapse may involve a 6-10 week course of oral prednisolone or addition of disease modifying therapy.
Disease modifying therapies used for IgG4-ROD include rituximab, methotrexate, azathioprine, mycophenolate mofetil, cyclosporine, mizoribine, and anti-TNFa inhibitors. In a systematic review, rituximab was the most commonly used disease modifying therapy and also had the highest response rate (93%) with low relapse rate (9%).[39] Suggested cycles of rituximab include two 1-g infusions separated by 14 days.[11][39] Patients may require more than one cycle of rituximab, or may experience relapse at 6 months when peripheral B-cells are re-populated.[11]Other immunosuppressants such as azathioprine and mycophenolate mofetil have had very limited success.[51]
Radiotherapy has been used with variable success in a limited number of cases.[40][14][52][53][39]
Medical follow up
Over half of patients diagnosed with IgG4-ROD will also have systemic IgG4-RD in other organs.[54][39] Therefore, arranging follow-up with a rheumatologist for these patients is advised in order to assess involvement of extra-orbital sites. Suggested work-up includes biochemical assessment of liver and renal function, as IgG4-RD may target these organs. CT scan (or MRI) of the head and neck, chest, abdomen, and pelvis is also recommended to exclude mass lesions in these areas. In particular, imaging is highly recommended for patients with bilateral IgG4-ROD, as there is a significant association between bilateral IgG4-ROD and having systemic disease.[55] Whole-body FDG-PET/CT may be used to stage IgG4-RD and to assess response to corticosteroid treatment.[54]
Surgery
Surgical biopsy of the lacrimal gland, orbital fat, or other involved tissues is employed to obtain a tissue sample for histopathological diagnosis. Surgical resection is typically not necessary unless patients have vision threatening symptoms from mass effect of lesions. However, a small case series of surgical resection alone found a recurrence rate of 13%, lower than typically reported for medical management.[56]
Complications
Patients with IgG4-ROD are at increased risk for lymphoma, particularly low-grade extranodal marginal zone B-cell lymphoma of mucosa-associated lymphoid tissue (MALT lymphoma).[18] Untreated IgG4-ROD affecting the lacrimal glands may also lead to irreversible damage and lifelong dry eye disease.[54]
References
- ↑ Hamano H, Kawa S, Horiuchi A, et al. High serum IgG4 concentrations in patients with sclerosing pancreatitis. N Engl J Med 2001;344:732-8.
- ↑ McNab AA, McKelvie P. IgG4-Related Ophthalmic Disease. Part I: Background and Pathology. Ophthal Plast Reconstr Surg 2015;31(2):83-88.
- ↑ 3.0 3.1 3.2 Divatia M, Kim SA, Ro JY. IgG4-related sclerosing disease, an emerging entity: a review of a multi-system disease. Yonsei Med J 2012;53:15-34.
- ↑ Stone JH, Zen Y, Deshpande V. IgG4-Related Disease. N Engl J Med 2012;366:539-551.
- ↑ 5.0 5.1 Plaza JA, Garrity JA, Dogan A, Ananthamurthy A, Witzig TE, Salomao DR. Orbital inflammation with IgG4-positive plasma cells, manifestation of IgG4 systemic disease. Arch Ophthalmol 2011;129:421-28.
- ↑ Andron A, Hostovsky A, Nair AG, et al. The impact of IgG-4-ROD on the diagnosis of orbital tumors: a retrospective analysis. Orbit. 2017;36(6):359-364.
- ↑ 7.0 7.1 Tsai CY, Kuo KT, Cheng AMS, et al. IgG-related ophthalmic disease in idiopathic sclerosing and non-sclerosing orbital inflammation: a 25-year experience. Curr Eye Res. 2019;44(11):1220-1225.
- ↑ Chen J, Zhang P, Ye H, et al. Clinical features and outcomes of IgG4-related idiopathic orbital inflammatory disease: from a large southern China-based cohort. Eye (Lond). 2020 Jul 13. doi:10.1038/s41433-020-1083-x.
- ↑ Guma M, Firestein GS. IgG4-related diseases. Best Pract Res Clin Rheumatol 2012;26:425-38.
- ↑ 10.0 10.1 Umehara H, Okazaki K, Masaki Y, et al. Comprehensive diagnostic criteria for IgG4-related disease (IgG4-RD), 2011. Mod Rheumatol 2012;22:21-30.
- ↑ 11.0 11.1 11.2 11.3 11.4 11.5 11.6 11.7 11.8 Wallace ZS, Deshpande V, Stone JH. Ophthalmic manifestations of IgG4-related disease: Single-center experience and literature review. Semin Arthritis Rheum 2014;43(6):806-17.
- ↑ Smerla RG, Rontogianni D, Fragoulis GE. Ocular manifestations of IgG4-related disease in children. More common than anticipated? Review of the literature and case report. Clin Rheumatol. 2018;37(6):1721-1727.
- ↑ Cheuk W, Yuen HK, Chan AC et al. Chronic sclerosing dacryoadenitis: part of the spectrum of IgG4-related Sclerosing disease? Am J Surg Pathol 2007;31:643-45. Go et al. 2012
- ↑ 14.0 14.1 14.2 Sato Y, Ohshima K, Ichimura K et al. Ocular adnexal IgG4-related disease has uniform clinicopathology. Pathol Int 2008;58:465-70.
- ↑ 15.0 15.1 Matsuo T, Ichimura K, Sato Y, et al. Immunoglobulin G4 (IgG4)-positive or -negative ocular adnexal benign lymphoid lesions in relation to systemic involvement. J Clin Exp Hematop 2010;50:129-142.
- ↑ Go H, Kim JE, Kim YA et al. Ocular adnexal IgG4-related disease: comparative analysis with mucosa-associated lymphoid tissue lymphoma and other chronic inflammatory conditions. Histopathology 2012;60:296-312.
- ↑ Sogabe Y, Ohshima K, Azumi A, et al. Location and frequency of lesions in patients with IgG4-related ophthalmic diseases. Graefes Arch Clin Exp Ophthalmol 2014;252:531-8.
- ↑ 18.0 18.1 18.2 18.3 Kim KP, Kim MH, Song MH et al. Autoimmune chronic pancreatitis. Am J Gastroenterol 2004;99:1605-16.
- ↑ 19.0 19.1 Nishimori I, Tamakoshi A, Otsuki M. Prevalence of autoimmune pancreatitis in Japan from a nationwide survey in 2002. J Gastroenterol 2007;Suppl 18:6-8.
- ↑ Andrew N, Kearney D, Selva D. IgG4-related orbital disease: a meta-analysis and review. Acta Ophthalmol 2013;91(8):694-700.
- ↑ Masaki Y, Dong L, Kurose N et al. Proposal for a new clinical entity, IgG4-positive multiorgan lymphoproliferative syndrome: analysis of 64 cases of IgG4-related disorders. Ann Rheum Dis 2009;68:1310-15.
- ↑ Matsui S, Taki H, Shinoda K et al. Respiratory involvement in IgG4-related Mikulicz’s disease. Mod Rheumatol 2012;22:31-9.
- ↑ Asproudis I, Kanari M, Ntountas I, et al. Successful treatment with rituximab of IgG4-related disease coexisting with adult-onset asthma and periocular xanthogranuloma. Rheumatol Int. 2020;40(4):671-77.
- ↑ Deshpande V, Zen Y, Chan JK et al. Consensus statement on the pathology of IgG4-related disease. Mod Pathol 2012;25(9):1181-92.
- ↑ Sogabe Y, Miyatani K, Goto R et al. Pathological findings of infraorbital nerve enlargement in IgG4-related ophthalmic disease. Jpn J Ophthalmol 2012;56:511-4.
- ↑ Kanari H, Kagami S, Kashiwakuma D et al. Role of Th2 cells in IgG4-related lacrimal gland enlargement. Int Arch Allergy Immunol 2010;152(Suppl. 1):47-53.
- ↑ Yamada K, Kawano M, Inoue R et al. Clonal relationship between infiltrating immunoglobulin G4 (IgG4)-positive plasma cells in lacrmimal glands and circulating IgG4-positive lymphocytes in Mikulicz’s disease. Clin Exp Immunol 2008;152(432-439).
- ↑ Harrison JD, Rodriguez-Justo M. Commentary on IgG4-related sialadenitis: Mikulicz’s disease, Kuttner’s tumour, and eponymy. Histopathology 2011;58(7):1164-6.
- ↑ 29.0 29.1 Sane M, Chelnis J, Kozielski R, Fasiuddin A. Immunoglobulin G4-sclerosing disease with orbital inflammation in a 12-year-old girl. J AAPOS 2013;17(5):548-50.
- ↑ Ohshima K, Sogabe Y, Sato Y. The usefulness of infraorbital nerve involvement in idiopathic orbital myositis. Ophthal Plast Reconstr Surg 2002;18:474-8.
- ↑ Katsura M, Morita A, Horiuchi H, et al. IgG4-related inflammatory pseudotumor of the trigeminal nerve: another component of IgG4-related sclerosing disease? AJNR Am J Neuroradiol 2011;32:E150-2.
- ↑ Yokoi S, Kawagashira Y, Ohyama K, et al. Mononeuritis multiplex with tumefactive cellular infiltration in a patient with reactive lymphoid hyperplasia with increased immunoglobulin G4-positive cells. Hum Pathol 2014;45:427-30.
- ↑ Inoue D, Zen Y, Sato Y et al. IgG4-related perineural disease. Int J Rheumatol 2012;2012:401890.
- ↑ Li A, Plesec TP, Mileti L, Singh AD. Isolated conjunctival inflammation as a manifestation of IgG4-related disease. Cornea. 2018;37(9):1182-1184.
- ↑ Mavrommatis MA, Avila SA, France R. IgG4-related ophthalmic disease presenting as meningitis and panuveitis. Case Rep Ophthalmol Med. 2019:5653282.
- ↑ Shimizu Y, Yamamoto M, Naishiro Y et al. Necessity of early intervention for IgG4-related disease-delayed treatment induces fibrosis progression. Rheumatology 2013;52(4):679-83.
- ↑ Mehta M, Jakobiec F, Fay A. Idiopathic fibroinflammatory disease of the face, eyelids, and periorbital membrane with immunoglobulin G4-positive plasma cells. Arch Pathol Lab Med 2009;133:1251-55.
- ↑ Karamchandani JR, Younes SF, Warnke RA, Natkunam Y. IgG4-related systemic sclerosing disease of the ocular adnexa: a potential mimic of ocular lymphoma. Am J Clin Pathol 2012;137:699-711.
- ↑ 39.0 39.1 39.2 39.3 39.4 39.5 39.6 39.7 Detiger SE, Karim AF, Verdijk RM, et al. The treatment outcomes in IgG4-related orbital disease: a systematic review of the literature. Acta Ophthalmol. 2019;97(5):451-459.
- ↑ 40.0 40.1 40.2 Kalapesi FB, Garrott HM, Moldovan C, Williams M, Ramanan A, Herbert HM. IgG4 Orbital Inflammation in a 5-year-old Child Presenting as an Orbital Mass. Orbit 2013;32(2):137-40.
- ↑ Park J, Lee MJ, Kim N, et al. Risk factors for extraophthalmic involvement and treatment outcomes in patients with IgG4-related ophthalmic disease. Br J Ophthalmol. 2018;102(6):736-741.
- ↑ Toyoda K, Oba H, Kutomi K et al. MR imaging of IgG4-related disease in the head and neck and brain. AJNR Am J Neuroradiol 2012;33(11):2136-9.
- ↑ Masaki Y, Kurose N, Umehara H. IgG4-related disease: a novel lymphoproliferative disorder discovered and established in Japan in the 21st century. J Clin Exp Hematop 2011;51:13-20.
- ↑ Umehara H, Okazaki K, Masaki Y et al. Comprehensive diagnostic criteria for IgG4-related disease (IgG4-RD), 2011. Mod Rheumatol 2012;22:21-30.
- ↑ Goto H, Takahira M, Azumi A et al. Diagnostic criteria for IgG4-related ophthalmic disease. Jpn J Ophthalmol 2015;59:1-7.
- ↑ Ebbo M, Daniel L, Pavic M et al. IgG4-related systemic disease: features and treatment response in a French cohort: results of a multicenter registry. Medicine 2012;91(1):49-56.
- ↑ Sah RP, Chari ST. Serologic issues in IgG4-related systemic disease and autoimmune pancreatitis. Curr Opin Rheumatol 2011;23:108-113.
- ↑ 48.0 48.1 48.2 Abraham M and Khosroshahi A. Diagnostic and treatment workup for IgG4-related disease. Expert Rev Clin Immunol. 2017;13(9):867-875.
- ↑ Woo YJ, Kim JW, Yoon JK. Clinical Implications of serum IgG4 levels in patients with IgG4-related ophthalmic disease. Br J Ophthalmol 2017;101:256-260.
- ↑ Wu A, Andrew NH, McNab AA, et al. IgG4-related ophthalmic disease: pooling of published cases and literature review. Curr Allergy Asthma Rep 2015;15:530.
- ↑ Khosroshahi A, Stone JH. Treatment approaches to IgG4-related systemic disease. Curr Opin Rheumatol 2011;23(1):67-71.
- ↑ Kubota T, Moritani S, Katayama M, Terasaki H. Ocular adnexal IgG4-related lymphoplasmacytic infiltrative disorder. Arch Ophthalmol 2010;128:577-584.
- ↑ Kubota T, Moritani S, Yoshino T, Nagai H, Terasaki H. Ocular adnexal marginal zone B cell lymphoma infiltrated by IgG4-positive plasma cells. J Clin Pathol 2010;63:1059-65.
- ↑ 54.0 54.1 54.2 McNab A, McKelvie P. IgG4-Related Ophthalmic Disease. Part II: Clinical Aspects. Ophthal Plast Reconstr Surg 2015;31(3):167-78.
- ↑ Wu A, Andrew NH, McNab AA, Selva D. Bilateral IgG4-related ophthalmic disease: a strong indication for systemic imaging. Br J Ophthalmol 2016;100:1409-11.
- ↑ Ominato J, Oyama T, Cho Hiroyuki, et al. The natural course of IgG4-related ophthalmic disease after debulking surgery: a single-centre retrospective study. BMJ Open Ophthalmol. 2019;4(1):e000295.